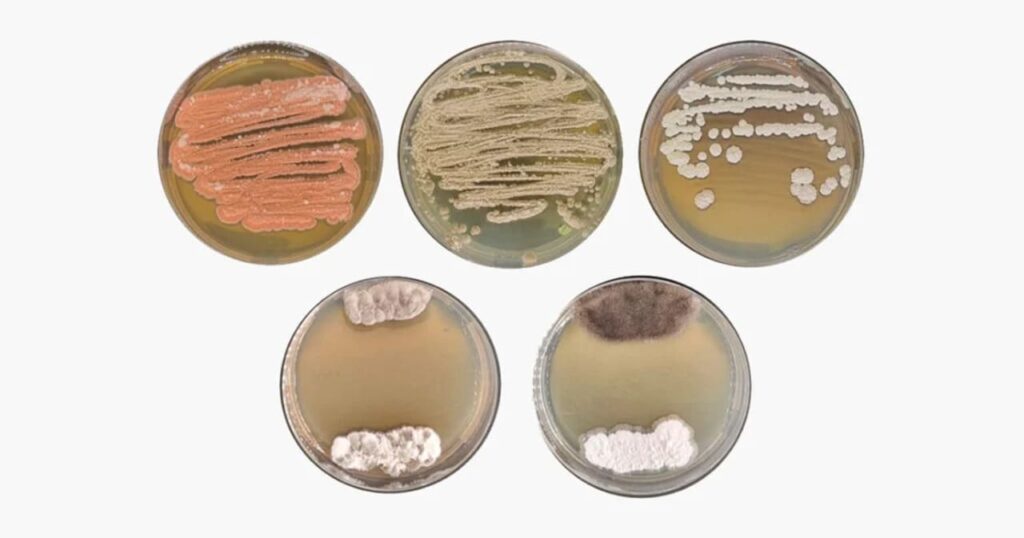
Microrganismos da Amazônia podem revolucionar agricultura e farmacologia

Poucos ambientes do planeta reúnem uma riqueza biológica tão vasta e ainda pouco explorada como a Floresta Amazônica. Esse imenso patrimônio natural, além de sua exuberância vegetal e animal, também abriga um universo invisível: o dos microrganismos. Recentemente, pesquisadores brasileiros e canadenses revelaram que esse microbioma pode ser uma chave poderosa para o desenvolvimento de novas soluções agrícolas e farmacêuticas.
O estudo foi conduzido por cientistas da Escola Superior de Agricultura Luiz de Queiroz (Esalq/USP), com a colaboração da Universidade de São Paulo (campus de São Carlos) e da Simon Fraser University, no Canadá. O foco do trabalho foram as actinobactérias — um grupo de microrganismos já conhecido por sua capacidade de produzir metabólitos com propriedades bioativas, mas que, nesse caso, foram isoladas diretamente dos solos amazônicos.
O projeto, que contou com o apoio da Fundação de Amparo à Pesquisa do Estado de São Paulo (FAPESP), investigou centenas de linhagens armazenadas no Laboratório de Genética de Microrganismos da Esalq. A análise incluiu uma abordagem interdisciplinar que envolveu microbiologia, genética e química orgânica, permitindo explorar em profundidade o comportamento metabólico dessas bactérias em diferentes contextos.
O solo amazônico como fonte de inovação
A pesquisa recorreu a técnicas de metabolômica e genômica para entender como esses microrganismos interagem com o ambiente e com outras espécies. Foi nesse processo que duas linhagens chamaram a atenção dos cientistas. Uma delas, da espécie Streptomyces sp. AM25, demonstrou ser altamente eficaz no estímulo ao crescimento de plantas, especialmente milho. Mais do que isso: mostrou habilidade em inibir o avanço de fungos nocivos a culturas agrícolas estratégicas como soja e tomate.
Enquanto isso, a outra linhagem analisada — Streptantibioticus sp. AM24 — revelou um potencial ainda mais inusitado. Ela produziu compostos inéditos, incluindo duas acidifilamidas completamente novas, tripeptídeos de estrutura química rara. Uma das moléculas apresentava uma modificação até então nunca observada entre metabólitos oriundos de microrganismos, o que a torna especialmente interessante para aplicações farmacêuticas e industriais.
Bioinsumos e o futuro da agricultura sustentável
A descoberta dessas actinobactérias representa uma oportunidade concreta de avanço para a agricultura sustentável. O uso de microrganismos como bioinsumos — substituindo defensivos químicos por alternativas biológicas — é uma estratégia em expansão no Brasil e no mundo. No caso da Streptomyces AM25, a combinação entre estímulo ao crescimento vegetal e resistência a patógenos pode reduzir a dependência de agrotóxicos e fertilizantes sintéticos.
Além disso, a diversidade genética dos microrganismos amazônicos é tão ampla que os especialistas acreditam que muitos outros compostos ainda estão por ser descobertos. A própria capacidade dessas bactérias de se adaptar a condições extremas do solo tropical, como alta acidez, umidade e complexidade orgânica, reforça seu valor como modelo para novas tecnologias.